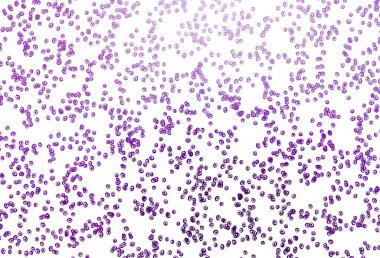
Lekeli açık mor vektör kapağı. Bulanık yağmur damlaları olan soyut bir çizim. Güzel web siteleri için desen.
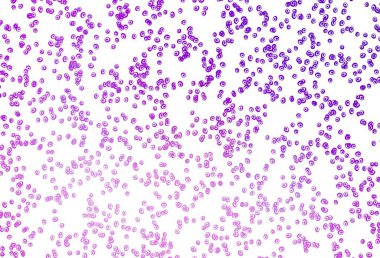
Disklerle vektör dokusu. Doğa tarzında bulanık halkaları olan güzel bir illüstrasyon. İş reklamları için tasarım.

Yeşil Leopar Kusursuz Desen. Suluboya El Çita Yazısı. Vahşi Cilt Egzotik Doku. Geometrik Kürk arka planı. Leopar ve Jaguar Deri. Suluboya El Boyalı Cilt Deseni.
İhlal Bildirim Formu

Özel Boyut
(4000 x 3000, jpg)
Geniş Lisanslama
(4000 x 3000, jpg)
* Kurumsal aylık abonelikte çok avantajlı fiyatlar için tıklayın.
* Fiyatlara Kdv dahil değildir.
Örnek Kullanımlar: Web siteleri; reklam afişleri; ekran koruyucuları; sunumlar (PowerPoint, Flash, vs); filmler, videolar veya televizyon reklamları, gazete ve dergilerdeki reklamlar, bastırılmış reklam materyalleri; kitaplar için kapak, iş kartları; el ilanları; posterler; CD/DVD kapakları, etiketler veya ürün paketleri, kırtasiye, dosya, defterler, tükenmez kalem, kalemler, yapıştırmalar; takvimler; fincanlar veya bardaklar; fare altlığı; tişörtler, kıyafet vs. Detaylı Tablo için Tıklayınız!
En Çok Aranan Kelimeler
yeşilArkaplanresimlemeZümrütparlaksanatBaharSoyutdokuHayvan.DesensiluetBiçimVintageKusursuz.DeriEl.modasuluboyaboyaAfrikalıtropikSafari.ciltHarika.KürkboyalıormanDuvar KağıdıgeometrikVahşikarıştırmaYazdırSörfAfrikasıçramaknaneKamuflajleoparkireçetnikkabileNeoneğilimÇita.AdaçayıyeşimJaguarDeniz köpüğüBenzer İçerikler


Özel Boyut
(4000 x 3000, jpg)
Geniş Lisanslama
(4000 x 3000, jpg)
Eser Sahibi:
Tarih:
Warning: substr_count(): Empty substring in /home/lisansio/public_html/wp-content/themes/telifport_v3/inc-frontend/modal-urun-bilgileri.php on line 288